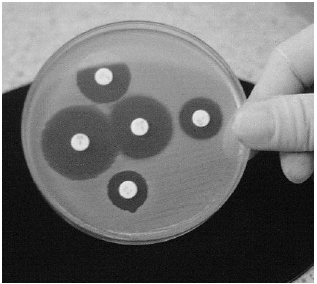

Services on Demand
Journal
Article
Indicators
-
 Cited by SciELO
Cited by SciELO -
 Access statistics
Access statistics
Related links
-
 Cited by Google
Cited by Google -
 Similars in
SciELO
Similars in
SciELO -
 Similars in Google
Similars in Google
Share
Revista Ciencias de la Salud
Print version ISSN 1692-7273On-line version ISSN 2145-4507
Rev. Cienc. Salud vol.4 suppl.1 Bogotá Oct. 2006
Infecciones recurrentes por staphylococcus aureus en paciente con piercing nasal asociado al estado de portador: estudio de caso
Recurrent Infections by Staphylococcus Aureus in Patients with Nasal Piercing Associated to the State of the Carrier. Study of Case
José Nel Carreño*, María Antonia Gaona**, María Cristina Peña, Dora Inés Ríos, Carolina Rivera§
* Médico, Espec. Neurocirugía. Fundación Santa Fé.
** Bacterióloga. Universidad del Rosario.
María Cristina Peña. Bacterióloga. Universidad del Rosario
Dora Ines Ríos. Bacterióloga. Universidad del Rosario.
§ Carolina Rivera. MD. Universidad del Rosario.
Recibido: 04 de septiembre de 2006. Aceptado: 25 de septiembre de 2006.
PRESENTACIÓN DEL CASO CLÍNICO
Paciente de sexo femenino de veinte años de edad, natural y procedente de Bogotá, D.C., quien consulta por cuadro clínico de 8 días de evolución consistente en aparición de masa indurada localizada en línea media de la región lumbar a nivel de la quinta vértebra, con eritema y dolor. Antecedentes patológicos: asma en la infancia, acné juvenil y sinusitis crónica. Tóxicos: fumadora ocasional de dos cigarrillos al día desde hace dos años. Además, se realizó una perforación o piercing nasal donde usa un adorno metálico desde hace un año. La masa ha aumentado de tamaño tornándose más dolorosa e impidiendo parcialmente la bipedestación. Desde hace tres días refiere presencia de escaso exudado purulento, sin más síntomas relevantes. Examen físico: Paciente de aspecto saludable, afebril, que presenta en la línea media de la región lumbar masa renitente de 4x5 cm., con calor, rubor y dolor. Se aprecia secreción de material purulento, por lo que se hace diagnóstico de absceso piógeno. Se decide drenarlo manualmente obteniendo pus, sin olor desagradable, el cual se envía al laboratorio para frotis, cultivo y prueba de sensibilidad a los antimicrobianos. Adicionalmente, se toman muestras de fosas nasales, faringe y manos para investigar el estado de portador de Staphylococcus aureus. Se inicia tratamiento antibiótico empírico con dicloxacilina oral 500 mg cada ocho horas por siete días. La tinción de Gram directa muestra abundantes leucocitos y cocos Gram positivos agrupados en racimos. Se siembran las muestras en agar sangre de cordero al 5% y se incuban a 37°C. A las cuarenta y ocho horas se obtiene crecimiento de un Staphylococcus, tanto de la muestra obtenida del absceso como de las fosas nasales, confirmándose mediante las pruebas de clasificación Staphylococcus aureus. Se hacen pruebas de sensibilidad a los antimicrobianos por la técnica Kirby– Bauer en difusión en agar, presentando las dos cepas el mismo patrón de sensibilidad a clindamicina, trimetropim-sulfametoxazol, oxacilina, vancomicina y cefalosporinas de primera generación; no presentan resistencia a ningún antimicrobiano. Los cultivos de faringe y piel presentaron crecimiento de flora bacteriana normal.
La paciente vuelve a los dos días refiriendo fiebre no cuantificada, aumento del tamaño de la lesión y persistencia de la secreción. Se punciona y se obtienen 10 ml de pus y se continúa con el mismo manejo antibiótico. La paciente continúa con drenaje espontáneo de escaso material purulento, por lo que es necesario realizar incisión de aproximadamente 1 cm de longitud para permitir el drenaje completo del absceso. Se continúa con el mismo tratamiento antibiótico hasta completar doce días. Se recomienda realizar curaciones diarias y retirar el adorno metálico nasal. Al cabo de dos semanas presenta resolución completa de la lesión.
Dos meses más tarde la paciente consulta nuevamente por cuadro clínico de veinticuatro horas de evolución consistente en aparición de absceso en párpado inferior del ojo izquierdo, con dolor, calor y eritema local. Durante el examen físico la paciente está afebril y se evidencia masa indurada de 3x4 mm. localizada en párpado inferior del ojo izquierdo dolorosa a la digitopresión, con eritema, calor local y punto de drenaje con escasa salida de material purulento. Se hace diagnóstico de chalazión.
Se retira el adorno metálico nasal, pues la paciente sigue con él, y se toman muestras de la secreción ocular y de las fosas nasales para cultivo y pruebas de sensibilidad. El adorno metálico también se cultiva. Se inicia tratamiento con dicloxacilina 500 mg cada ocho horas por siete días, tiempo durante el cual presenta drenaje espontáneo del absceso y resolución completa del cuadro clínico.
RESULTADO DEL LABORATORIO
Se aísla Staphylococcus aureus de todas las muestras cultivadas con el mismo patrón de susceptibilidad de las cepas iniciales.
Figura 1. Staphylococcus aureus aislado en absceso, chalazion, fosa nasal y piercing. Cultivo en agar sangre-cordero

Figura 2. Prueba de sensibilidad antimicrobiana, técnica de Kirby-Bauer
DISCUSIÓN
El Staphylococcus aureus es un microorganismo Gram positivo responsable de un amplio rango de procesos infecciosos en piel, tejido celular subcutáneo, hueso y articulaciones, septicemia, endocarditis y neumonía. La mucosa de las fosas nasales se considera reservorio de S. aureus y el ser portador de este microorganismo parece tener un papel importante en la patogénesis de la infección de origen endógeno. En los pacientes con bacteremia por S. aureus hay una fuerte correlación entre las cepas que colonizan la mucosa nasal y las cepas aisladas de la sangre. Esto sugiere el origen endógeno de la bacteremia (1).
Entre los factores de riesgo conocidos para colonización por S. aureus se encuentran la edad, (mayor incidencia en niños), sexo, hospitalizaciones, uso de antibióticos, alteraciones anatómicas de la nasofaringe, algunas enfermedades como la sinusitis crónica, antecedente de infecciones por S. aureus y factores conductuales como la drogadicción por vía endovenosa, los tatuajes y las perforaciones corporales para la colocación de adornos.
El piercing o perforación corporal ha ganado popularidad y aceptación social en las últimas décadas con el consecuente incremento de las complicaciones derivadas de esta práctica. La utilización de adornos como barras de acero, aros y agujas a través de superficies cutáneas y mucosas permite la penetración de diversos microorganismos patógenos hacia el tejido celular subcutáneo (2). El lóbulo de la oreja es el sitio donde, desde hace muchos años, se ha practicado, pero ahora cada vez más se realiza en otras localizaciones como en las cejas, labios, nariz, lengua, pezones, ombligo y área genital (3).
Los riesgos que se derivan de esta práctica pueden clasificarse en no infecciosos e infecciosos. Dentro de los primeros están el sangrado agudo y la formación de queloides, y en los segundos, la colonización e infección bacteriana en el sitio de la perforación (4,5), que puede ser ocasionada por Staphylococcus aureus, Pseudomonas aeruginosa y Streptoccoccus pyogenes. Estos microorganismos podrían provenir de la colonización transitoria o permanente del paciente constituyéndose en fuente endógena o de origen exógeno por contacto con otros portadores (2, 5). Hasta el momento no se habían recuperado bacterias anaerobias en este tipo de infecciones. Sin embargo, en recientes trabajos se han demostrado algunos casos de infecciones por estos microorganismos en sitios del cuerpo perforados: pezón, ombligo y tabique nasal (2), así como también la transmisión de agentes virales como el VIH, Hepatitis B, C y D. Se considera que el 10 o el 20% de estas perforaciones se complican con una infección local bacteriana la cual, dependiendo de otros factores predisponentes, puede diseminarse e iniciar un cuadro sistémico que puede llevar incluso a la muerte (5, 6). Si el piercing se realiza en una membrana mucosa puede producir bacteremia e incluso endocarditis bacteriana en personas con o sin antecedente de enfermedad valvular o cardiopatía congénita (7).
Se sabe que al erradicar el estado de portador nasal de S. aureus disminuye el riesgo de infecciones de origen endógeno (8). Reagan y su equipo de investigación (9) demostraron que la mupirocina tópica aplicada en las fosas nasales elimina el estado de portador, sin embargo, la recolonización ocurre en un corto periodo de tiempo (9).
Aunque pocos casos de infección postpiercing han sido reportados, posiblemente en un futuro este tipo de infección será más frecuente debido a la gran popularidad que ha ad quirido esta práctica. Por lo tanto, se sugiere que al hacer la historia clínica y examinar a un paciente que presente infecciones ya sea en tejidos superficiales, o sistémicos como endocarditis o hepatitis de origen desconocido, se investigue la presencia de un piercing corporal (5).
COMENTARIO
El Staphylococcus aureus es un patógeno Gram positivo que puede estar presente en la piel y membranas mucosas del ser humano, siendo las fosas nasales el sitio de colonización más frecuente donde se adhiere a la mucosa y se multiplica con facilidad (8). Por consiguiente, se puede aislar tanto en pacientes infectados como en portadores asintomáticos (10). El estado de portador nasal de S. aureus, es un factor de riesgo para presentar enfermedades producidas por este microorganismo, así como la principal fuente de infecciones nosocomiales (11).
El S. aureus se adhiere a la mucosa nasal mediante componentes de su pared celular como los ácidos teicoicos y lipoteicoicos, proteínas de unión a la fibronectina y polisacáridos capsulares. Los proteoglicanos y las glicoproteinas de la membrana de las células eucariotas también contribuyen a la adhesión bacteriana, haciéndose ésta más fácil en las células que tienen una cubierta de mucina que en aquellas que carecen de ella (8).
Para que un individuo sea colonizado por S. aureus debe entrar en contacto directo con el microorganismo. Se sabe que el mecanismo de transmisión es de persona a persona a partir de individuos infectados o de portadores asintomáticos. La transmisión aérea no es tan frecuente, pero puede ocurrir al estar en contacto con pacientes con neumonía estafilocóccica. Recientemente se ha establecido que los individuos portadores de este microorganismo, en el curso de infecciones virales respiratorias altas, expulsan S. aureus al aire. Por otra parte, también es posible la transmisión por contacto indirecto a través de objetos inanimados (12) y de paciente a paciente por las manos de los trabajadores hospitalarios que no cumplen las normas de bioseguridad y de asepsia y antisepsia (13).
Los portadores asintomáticos de S. aureus pueden padecer una infección producida por éste cuando se altera la barrera mucocutánea, especialmente por traumatismos o laceraciones. A partir de esta fuente endógena, S. aureus, que se comportaba hasta entonces como comensal, se rompe el delicado equilibrio que impedía su capacidad de proliferación y ocasiona una infección que puede presentarse como local o generalizada, dependiendo de factores propios del huésped, del tipo de infección y de la precocidad del tratamiento (10).
Mediante estudios microbiológicos de mucosa nasal realizados en individuos sanos ha sido posible diferenciar tres tipos de portadores de S aureus: el no portador, el portador intermitente y el portador persistente de una misma o de diferentes cepas del microorganismo. Esto puede deberse a factores del huésped y/o antagonismo entre los microorganismos de la flora nasal normal. En efecto, se ha observado una baja incidencia de colonización por S. aureus en individuos altamente colonizados por Corynebacterium spp como lo han confirmado experimentos in vivo. En individuos colonizados por Corynebacterium spp. y Staphylococcus no aureus, especialmente S. epidermidis, la colonización por S. aureus es significativamente menor que en individuos que no presentan Corynebacterium spp. Lo anterior sugiere que tanto Corynebacterium spp y el S. epidermidis, tienen acción antagónica sobre la colonización de S. aureus debido, posiblemente, a la síntesis de bacteriocinas, bacteriociocinas, enzimas bacteriolíticas, peróxido de hidrógeno, ácido láctico, ácidos grasos y amoniaco. Este antagonismo también puede producirse por competencia para receptores epiteliales específicos (14). Uehara y colaboradores en el 2000, sugirió que esta competencia por el sitio de unión puede involucrar la porción carbohidrato de la mucina nasal humana, y demuestran que el Corynebacterium spp. tiene más afinidad por el moco que el S. aureus, y que éste mayor que el S. epidermidis. Sin embargo, el papel fisiológico del moco es unirse a las bacterias y removerlas, y no la de promover la adhesión bacteriana al epitelio (15). Mongodin y sus compañeros de investigación, en el mismo año, demostraron que el S. aureus no se adhiere in vivo al moco del epitelio pero sí presenta adherencia a la membrana plasmática basolateral de las células columnares, a las células básales y a la membrana basal del epitelio (16).
A pesar de la gran cantidad de estudios realizados, hasta el momento no se ha identificado el mecanismo preciso de la interferencia bacteriana en la colonización nasal. Pero sí se ha establecido que el transportar en la mucosa nasal S. aureus, es un factor de riesgo importante para el desarrollo de infecciones por este microorganismo, ya que los portadores tienen mayor incidencia de infección que los no portadores. La cepa que causa la infección es usualmente la cepa de la cual se es portador y la erradicación del estado de portador disminuye el riesgo de desarrollar la infección (17).
Por lo tanto, es importante determinar los factores de riesgo que contribuyen a la colonización nasal por S. aureus. Uno de los factores, que ha sido identificado como determinante, es la edad. Es así como los recién nacidos presentan colonización por S. aureus entre un 59% al 100%, estos valores van disminuyendo hasta alcanzar del 10 al 35% a los 5 y 6 años de edad. Este factor fue establecido también por Lu y su equipo de investigación en 2005, encontrando que individuos con edades entre 0–10, 11–20 y 71–80 años estaban colonizados en el 37.6%, 27.3% y 24.4 % respectivamente (18). Además de la edad, el género resultó ser un importante factor de riesgo, habiéndose reportado que los varones se encuentran colonizados en mayor proporción que las mujeres (19). Desafortunadamente, las causas de esta asociación no se han establecido plenamente.
Algunos autores han descrito la sinusitis crónica como un factor de riesgo para la colonización por S. aureus. Sin embargo, una comparación de la flora normal de individuos sanos con la de pacientes con sinusitis crónica, no mostró una diferencia significativa en los índices de colonización por S. aureus. Sin embargo lo que si ha establecido es que la enfermedad en un portador es un factor que predispone la transmisión del microorganismo (19).
Numerosas investigaciones efectuadas sobre los portadores nasales de S. aureus, como las realizadas por Vandenbergh en 1999 y citadas por Herwaldt en 2003, han determinado que entre 20 y 55% (estudio corte transversal) y entre 10 y 35% (estudio longitudinal) de individuos adultos sanos son portadores de S. aureus en fosas nasales; del 20 al 75% son portadores intermitentes. La incidencia de los portadores nasales de S. aureus se ve incrementada por varios factores como son la rinosinusitis, uso de cocaína, descongestionantes tópicos y esteroides en aerosol. Cabe anotar aquí, que en pacientes con infecciones de piel producidas por S. aureus del 42 al 100% son portadores. Otros resultados no menos importantes muestran que la incidencia aumenta en pacientes con diabetes mellitus, tanto en los insulino-dependientes, como en los que están en programas de hemodiálisis o diálisis peritoneal (20). Se puede concluir que el estado de portador nasal de S. aureus juega un papel muy importante en la epidemiología y patogénesis de infecciones por este microorganismo de origen endógeno, tanto en individuos sanos como en aquellos que posean alguna patología subyacente.
REFERENCIAS
1. Von Eiff C, Becker K, Machka K, Stammer H, Peters G. Nasal Carriage as a Source of Staphylococcus aureus Bacteremia. N Engl J Med 2001; 344:11-16. [ Links ]
2. Brook I. Papel de las Bacterias Anaerobias en las Infecciones por Perforación Corporal con Fines Estéticos. Sociedad iberoamericana de Información Científica. 2003. [ Links ]
3. Domínguez A. Anillados (Piercing) y Tatuajes: ¿Prácticas de Riesgo?. Departament de Sanitat i Seguretat Social, Generalitat de Catalunya. 2001. [ Links ]
4. Weinberg JB, Blackwood RA. Case-Report of Staphylococcus aureus Endocarditis After Navel Piercing. The Pediatric Infectious Disease Journal. 2003; 22:94-95. [ Links ]
5. Tweeten S S M, Rickman L S. Infectious Complications of Body Piercing. Clin Infect Dis1998; 26: 735-40. [ Links ]
6. Guiard-Schmid JB, Picard H, Slama L, Maslo C, Amiel C, Pialoux G. Complications Liées aux Practiques du Piercing en France. Presse Med 2000; 29:1948-56. [ Links ]
7. Ramage I, Wilson N, Thomson R B. Fashion Victim: Infective Endocarditis After Nasal Piercing. Arch Dis Child 1997; 77:183. [ Links ]
8. Kluytmans J, Van Belkum A, Verbrugh H. Nasal Carriage of Staphylococcus aureus: Epidemiology, Underlying Mechanisms, and Associated Risks. Clinical Microbiology Reviews. 1997; 10:505-520 [ Links ]
9. Chen S. Staphylococcus aureus Decolonization. Concise Reviews of Pediatric Infectious Diseases. 2005; 24:79-80. [ Links ]
10. Camarena J. J, Sánchez R. Infección por Staphylococcus aureus Resistente a Meticilina. Departamento de Microbiología. Hospital Universitario Doctor Peset. Valencia. 1999. [ Links ]
11. Céspedes C, Saïd-Salim B, Millar M, Lo S-H et al.. The Clonality of Staphylococcus aureus Nasal Carriage. J Infect Dis. 2005; 191:444-52. [ Links ]
12. Ballesteros JV, Savio E, Rosa R, Lindner C, Savio M. Guía para el Manejo Global de las Infecciones por Staphylococcus aureus Meticilino Resistente de Origen Comunitario (SARM-com). Ministerio de Salud Pública. Uruguay. 2004. [ Links ]
13. Berthelot P, Grattard F, Fascia P, Martin I et al. F. Is Nasal Carriage of Methicillin-resistant Staphylococcus aureus More Prevalent Among Student Healthcare Workers?. Infect Control Hosp Epidemiol. 2004; 25: 364. [ Links ]
14. Lina G, Boutite F, Tristan A, Bes M, Etienne J, Vandenesch F. Bacterial Competition for Human Nasal Cavity Colonization: Role of Staphylococcal agr Alleles.. Appl.Environ.Microbiol. 2003; 69:18-23. [ Links ]
15. Uehara Y, Nakama H, Agematsu K, Uchida M et al. Bacterial interference among nasal inhabitants: Eradication of Staphylococcus aureus from Nasal cavities by Artificial Implantation of Corynebacterium spp. J Hosp Infect. 2000; 44:127-133. [ Links ]
16. Mongodin E, Bajolet O, Hinnrasky J, Puchelle E, De Bentzmann S. Cell Wall-Associated Protein A as a Tool for Immunolocalization of Staphylococcus aureus in Infected Human Airway epithelium. J Histochem Cytochem. 2000; 48:523-533. [ Links ]
17. Peacock SJ, Justice A, Griffiths D, De Silva GDI et al. Determinants of Acquisition and Carriage of Staphylococcus aureus in Infancy. J. Clin. Microbiol. 2003; 41:5718-5725. [ Links ]
18. Lu PL, Chin LC, Peng CF, Chiang YH et al. Risk Factors and Molecular Analysis of Community Methicillin-Resistant Staphylococcus aureus Carriage. J Clin Microbiol 2005:132-139. [ Links ]
19. Bischoff WE, Wallis ML, Tucker KB, Reboussin BA, Sherertz R. Staphylococcus aureus Nasal Carriage in a Student Community: Prevalence, Clonal Relationships, and Risk Factors. Infect Control Hosp Epidemiol. 2004; 25:485. [ Links ]
20. Herwaldt L A. Staphylococcus aureus Nasal Carriage and Surgical-Site Infections. Surgery. 2003; 134:5. [ Links ]














